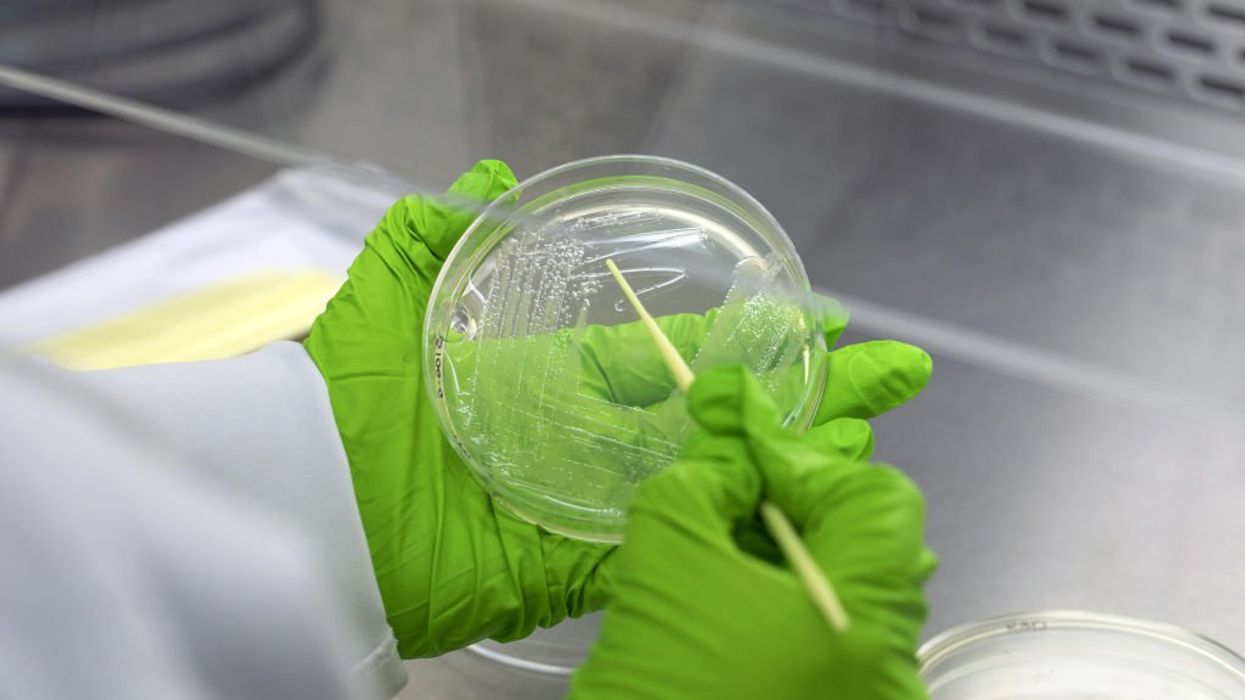
Is the medical establishment sabotaging the fight against chronic infections?

Getty Images/Bloomberg
Next-generation DNA sequencing offers hope but encounters resistance.
In 2016 a San Antonio police officer named Robert Taylor began to experience what’s politely termed “pelvic pain.” Generally this manifests as stabbing and burning sensations overlaid by a relentless, crushing pressure. In less clinical terms, it’s like a boa constrictor squeezing your genitals while simultaneously digesting them with its stomach acids.
Taylor recalls the experience as “hell on earth.” Much worse than the pain he felt when he was stabbed on duty.
Soon after the onset of the pain, he couldn’t work or sleep.
The culture and sensitivities testing his other doctors had run had long been the standard, but it had a failure rate of 40% to 70% for Robert’s condition.
He sought help immediately from a urologist. The doctor told Taylor he probably had a case of chronic bacterial prostatitis.
There was good news, though, as CBP is readily treatable. The doctor performed a rectal exam, took tissue samples, prescribed the standard antibiotics for CBP, and sent the specimens out for testing. He told Taylor that he ought to feel much better in about ten days. In the meantime, he also prescribed pain medications.
Taylor saw no improvement in ten days and received little relief from the pain medications. His physician reported that his test results came back negative or “within scope.” He would prescribe a broader-spectrum antibiotic.
Why hadn’t the test results revealed anything?
That often happened, the urologist admitted, even when there were clearly pathogens present. The testing had its limits. By prescribing a broader-spectrum antibiotic, his physician was resorting to the “empirical method.” Since traditional cultures fail so often to provide any diagnostic information, physicians prescribe antibiotics that have worked in the past to cure patients with similar symptoms. The “empirical method” boils down to making educated guesses.
As Taylor’s condition persisted, his life began to fall apart. The pain became all-consuming, leaving him withdrawn and self-absorbed. He began to worry about his sanity.
He tried a second urologist, then a third, then a fourth. Each performed the same rectal exam, wrote a prescription for one or more antibiotics, and assured him he ought to start feeling better soon.
This went on for two years. One day the fourth urologist, clearly exasperated by the lack of results, suggested that Taylor seek help from a psychiatrist, if only to improve his coping resources. Too tired to argue, Taylor simply left and never returned.
Now at his physical, emotional, and spiritual nadir, Taylor broke down one night and confessed to his wife that he was thinking of killing himself. He couldn’t bear the suffering or the burden that suffering was putting on others.
That’s when he found out about Dr. Timothy Hlavinka.
Hlavinka, a urologist with an international clientele, seemed able to help people like Taylor, whose conditions only puzzled and frustrated other physicians. Taylor made an appointment.
Hlavinka’s first recommendation had to do with diagnosis. The culture and sensitivities testing his other doctors had run had long been the standard, but it had a failure rate of 40% to 70% for Robert’s condition. Accuracy was actually slightly worse now that the process was automated, the only change in this technology since the Civil War era.
Hlavinka wanted to have Taylor tested by the Lubbock, Texas, lab of a company called MicroGen Diagnostics. The company's tests were based on running a DNA analysis of all the bacteria and fungi found in the specimen. The results would allow Hlavinka to prescribe more targeted antibiotics.

This made perfect sense to Taylor. DNA analysis had been used in law enforcement for 30 years. Why hadn’t this been done before?
The initial report from the test would be back within as little as 24 hours and the full report in about three days or five at most.
Taylor submitted urine samples (MicroGenDX’s testing can also use other common samples like blood, saliva, semen, and skin) and was told to expect an initial report within as little as 24 hours, followed by a full report in three to five days.
The initial report provides a qPCR (polymerase chain reaction) analysis, which amplifies small segments of RNA and then reverse-transcribes them into DNA. The process might be thought of as genetic photocopying. Many of us became familiar with qPCR tests during the COVID pandemic, as these were used to identify the virus. The initial report also indicates the total microbial load, as well as any antimicrobial resistance genes that may be present.
Like traditional C&S testing, qPCR tests will only find the pathogens specified by a given panel. In Taylor’s case, this meant only the “usual suspects” behind his prostatitis.
But for the full report, MicroGenDX also employs the more advanced sequencing technology known as next-generation sequencing. This produces results that can be compared against the company’s proprietary database of over 57,000 bacteria and fungi, including genetic variations, while screening for irrelevant data such as dust mites or any organic material accounting for under 2% of the total.
The full report ranks the relative “load” of each microbe as “low,” “medium,” or “high,” with an approximation of the DNA copies per gram. It also indicates the relative percentage of a given bacterium or fungus. This helps the physician distinguish between pathogens — disease-causing bacteria — and commensals, which exist in benign symbiosis with the body. It also provides a more extensive record of the drug-resistant genes present, while recommending antibiotics for effective treatment.
Taylor’s first MicroGenDX test showed four organisms. The primary bacteria were Acinetobacter lwoffii and E. coli, both undoubtedly pathogenic. The latter two, Massilia timonae and Finegoldia magna, were rare. Their role in Taylor’s condition would have to be determined through further analysis.

Hlavinka mainly knew they were in for a fight, since polymicrobial infections — infections in which two or more bacteria participate — can present mystifying challenges. But even this limited information left him less helpless than Taylor’s previous urologists.
Polymicrobial infections are frequently referred to as “biofilms.” This indicates the bonding of bacteria into a matrix that includes products from our bodies' attempts to thwart the infection. The bacteria not only cooperate but hijack the body’s protective measures to maintain their collective toxicity.
Another way to portray polymicrobial infections is as “colonies” that operate under a “calyx” or umbrella-like structure. Although the metaphor is inexact, we might imagine a polymicrobial infection as a nasty, exploitative off-planet mining colony with several types of workers operating under a protective dome.
The governance of the colony might also be compared to organized crime, with direction supplied by its dominant strains. Polymicrobial colonies even have their own form of “omerta,” or vow of silence. Bacteria have an uncanny ability to hide from detection.
Many of the ways in which bacteria keep hidden are not yet understood. A few discoveries have been made, however. For example, bacteria can hide in white blood cells, the very agents the body sends to attack them, often multiplying until they explode the cells apart in a kind of toxic storm. They can also hide within the cell walls of the organs they are infecting.
For patients like Taylor, the resistance to next-generation sequencing is puzzling if not infuriating. It also has larger ramifications for public health. Misdiagnosed infections result in ineffective antiobiotic prescription.
Such was the tenacious and elusive foe that had attached itself to the wall of Robert Taylor’s prostate, systematically stripping him of the will to live.
Taylor’s treatment extended over four different courses of antibiotics. Each was directed against the dominant strains of bacteria that showed up in a succession of MicroGenDX tests.
This did not surprise Hlavinka. Delay in proper diagnosis of a chronic infection allows polymicrobial colonies to become stronger and stronger, with more survival tactics at their disposal. Each course of antibiotics brought others out of hiding until the entire colony was obliterated. Taylor made a full recovery.
Hlavinka sees this as proof that extensive biofilms are behind the suffering of hard-to-treat patients like Taylor. “Nothing else explains the ‘treat one and another pops up’ phenomenon,” he says. And he has no doubt that he could never have helped Taylor using only traditional culture and the “empirical method.”
Taylor, now thriving both at home and at work, agrees.
“This is life-changing technology,” he says. “It kept me around for my wife and kids.”
DNA testing may have been used for decades in criminology — and every "Forensic Files" episode — but the U.S. medical establishment has resisted adopting its diagnostic use for bacterial and fungal infections for years. The insurance companies, hospital networks, doctors’ associations, and medical journals that guide conversations about the field show an unwillingness to replace C&S with next-generation sequencing.
This despite the widely accepted accuracy of NGS and the emergence of an industry eager to implement it. In addition to MicroGenDX, the Mayo Clinic and the University of Washington also offer NGS, if on a more limited basis and at greater cost. Then there’s Karius, an NGS service that works with blood samples. Even PCR-only services like BioSphere and Pathogenesis offer a measure of improvement over C&S alone.
For patients like Taylor, the resistance to NGS is puzzling if not infuriating. It also has larger ramifications for public health. Misdiagnosed infections result in ineffective antiobiotic prescription.
This in turn contributes to the evolution of “superbugs,” whose susceptibility to even the most advanced antibiotics is rapidly diminishing. According to the Lancet, 1.2 million people in 2019 died across 204 countries from anti-microbial resistance — people administered antibiotics that proved ineffective. The rate of death from AMR outpaced mortality from HIV/AIDS or malaria.
Nor is help from new antibiotics on the way. As the headline of a recent "Wall Street Journal" article declares, “The World Needs New Antibiotics. The Problem Is, No One Can Make Them Profitably. New drugs to defeat ‘superbug’ bacteria aren’t reaching patients.”
Two major sources of resistance to NGS adoption are Labcorp and Quest, the dominant players in the $7 billion-a-year U.S. diagnostic testing market. Both companies have “leakage” provisions in their contracts that penalize customers who send out too high a percentage of specimens to competing laboratories.
There’s also medical skepticism. The comprehensive microbial detection that NGS enables could just as easily exacerbate over-prescription of antibiotics, with the attendant increase in anti-microbial resistance.
A good summary of this argument can be found in the American Urological Association’s 2022 guideline for treating urinary tract infections: "Sensitive detection of microorganisms [from molecular testing] will likely be associated with increased diagnostic confusion and dilemmas, including overdiagnosis and associated overtreatment."
While the authors also admit that “molecular testing technologies have the potential to provide accurate and rapid information, and hold promise for the future,” they conclude by cautioning that “more evidence is needed before these technologies become incorporated into the guideline …”
This guidline has been widely used by private insurance companies to deny coverage for NGS testing by classifying it as “investigational/experimental,” even after the American Medical Association and the Centers for Medicare and Medicaid Services accepted the use of MicroGenDX testing as “medically necessary” in 2019.
Dr. Alan Wolfe, professor of microbiology at the Stritch School of Medicine at the University of Loyola, heads the Wolfe Lab, conducting research into the female urinary microbiome.
Wolfe is no fan of traditional testing, which he says “sucks.” He decries the efforts of entrenched interests to keep it the “gold standard” of care for chronic UTIs — or, in fact, a standard at all. “I would never use an assay and a test like that. It's a tool, but it's not a gold standard.”
And yet he agrees with the guideline's concerns about “diagnostic confusion.”
“It’s not that it’s a bad idea,” Wolfe says. “It’s just before its time. There's too much information and not enough information. Right now, it’s like trying to drink from a firehose.”
Dr. Wolfe believes we are in a time of transition between a clearly outmoded diagnostic testing technology and molecular testing that relies on a greater knowledge base.
“We’ve just killed the old dogma, but we don’t know what the new truth is.” Dr. Wolf says that maintaining successful implementation of NGS will require much greater understanding of the microbiome and how individual differences in immune systems result in biofilms or pathogenic colonies forming.
For now, Wolfe recommends PCR testing as a compromise. (Wolfe serves as a scientific adviser to Pathnostics, which offers PCR testing.)
Other doctors believe that the benefits of NGS testing outweigh the risks, provided that it is interpreted with appropriate prudence.
Dr. Javad Parvizi is a world-renowned expert in orthopedic infections who has performed over 10,000 hip and knee replacements as well as their “revisions,” or secondary surgeries where part or all of the hardware implanted has failed.
An outcome-based study Parvizi and colleagues recently published in Clinical Infectious Diseases claims that NGS improves antibiotic stewardship through providing far more accurate results.
Before knee or hip replacement surgery, antibiotics are administered prophylactically to prevent post-surgical periprosthetic (prosthesis-related) infections. Parvizi asserts that in his experience, in 30% to 40% of patients, traditional testing fails to provide guidance for the administration of these antibiotics. The subsequent “blind” treatment greatly increased the risk of post-operative infections and promoted the over-prescription of antibiotics.
A new paper from Frontiers in Cellular and Infection Microbiology by Kaipeng Jia, Shiwang Huang, et al. echoes this conclusion: “mNGS has shown significant advantages over traditional culture, particularly in the context of mixed infections and UTIs that are difficult to diagnose and treat. It helps to improve the detection of pathogens, guide changes in treatment strategies, and is an effective complement to urine culture.”
Would physicians who do not practice in such advanced research facilities enjoy similar success? This question troubled Tucson-based infectious disease specialist Dr. Clifford Martin. He was especially worried that the siloed nature of medicine actively encourages over-prescription of drugs across narrow specialties.
After successfully treating chronic UTIs and prosthetic joint infections with NGS, Dr. Martin’s concerns changed focus.
“Infectious disease doctors who understand the molecular testing and the nuances of making diagnoses based on ambiguous information should really be championing the appropriate use of it,” Martin says. “They should be rolling it out widely in areas where patients are truly suffering or where there's diagnostic difficulty. The technology wasn’t the problem. The problem was educating our colleagues on what it is and how to use it appropriately.”
Hlavinka agrees. He keeps an informal tally of how many doctors each of his patients has seen prior to him and how many traditional cultures they’ve had run. The current record is 23 doctors and 54 traditional cultures. One can only imagine how many rounds of antibiotics this amounts to.
According to Hlavinka, the relief his patients feel is often accompanied by another emotion: anger. When they hear that he’s been using MicroGenDx’s NGS testing for six years, they can’t help but rage at the suffering they could have avoided. “They need to vent.”
- YouTubeyoutu.be